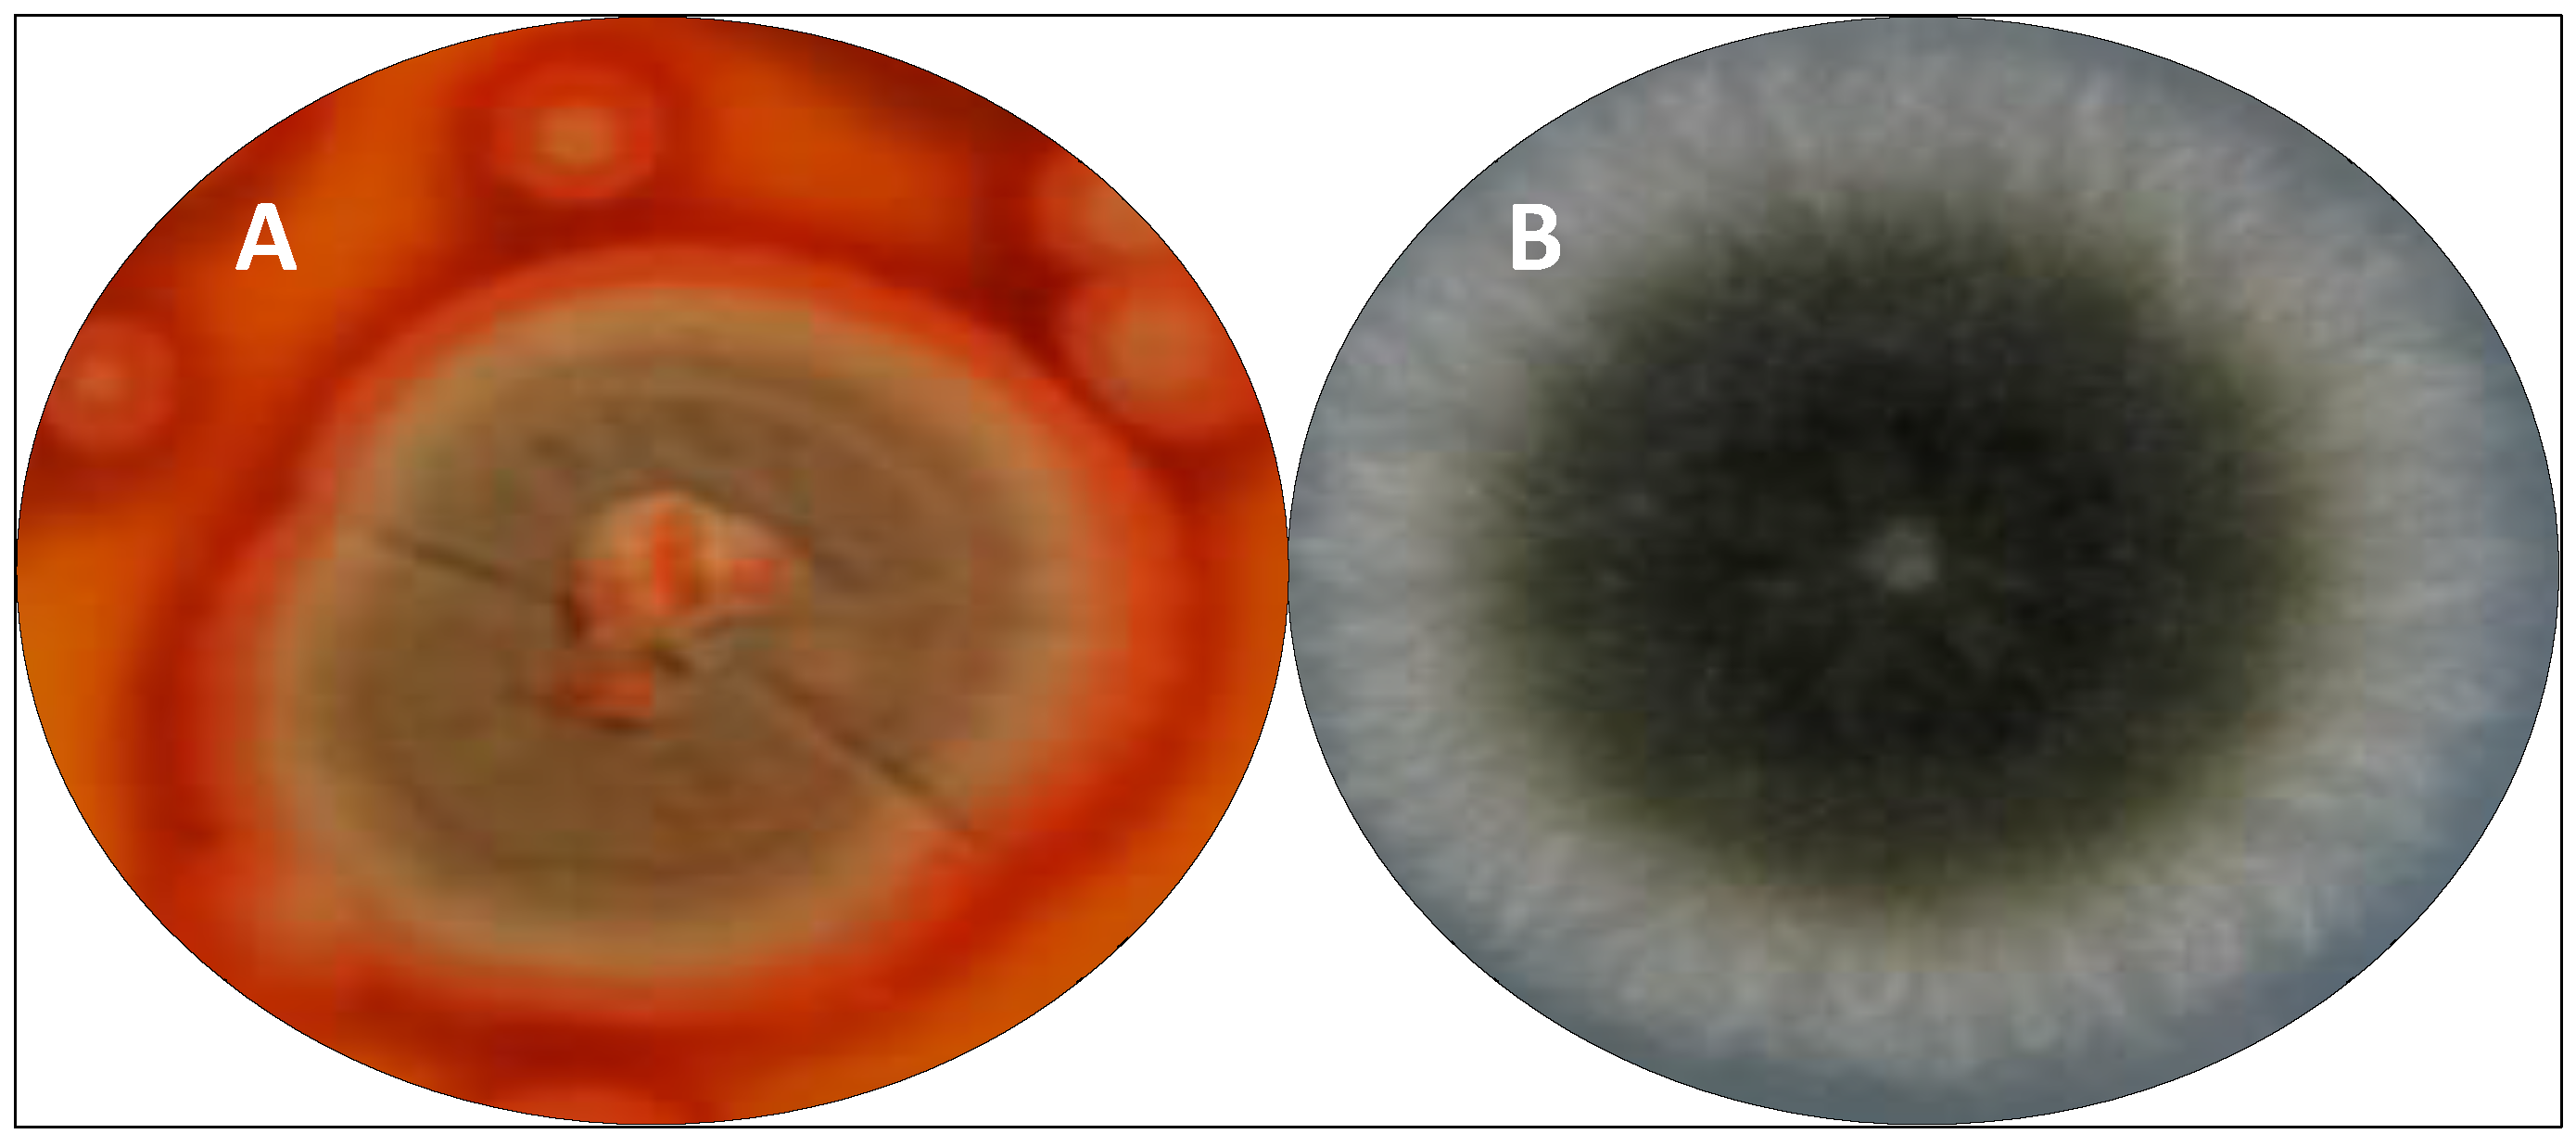
Antibiotics 11 01604 g006 Antibiotics 11 01604 g006

Overview of Bioactive Fungal Secondary Metabolites: Cytotoxic and Antimicrobial Compounds
Abstract
1. Introduction
2. Obtaining Microorganism Strains for Biosynthesis of Bioactive Secondary Metabolites
3. Obtaining Fungal Secondary Metabolites and Structural Characterization
4. Aspects of Secondary Metabolism Pathways in Microorganisms
5. Bioactive Fungal Secondary Metabolites and Derivatives Successfully Applied by the Pharmaceutical and Agrochemical Companies
6. Studies of Fungal Secondary Metabolites as Cytotoxic and Antimicrobial Agents
6.1. Cytotoxic Compounds
| Metabolites | Fungi Species | References |
|---|---|---|
| Bislongiquinolide (trichotetronine), dihydrotrichodimerol | T. citrinoviride | [124] |
| Paclitaxel | B. robillardoides L. theobromae Paraconiothyrium sp. P. microspore P. neglecta P. versicolor T. andreanae | [128,129,130,131,132,133] |
| Camptothecin, podophyllotoxin, vinblastine, vincristine | T. radicus | [134] |
| Altenuene, stemphyperylenol | Botryosphaeriadothidea | [135] |
| Alterperylenol, altertoxin II | Alternaria sp. A744 | [136] |
| Alterperylenol, stemphyperylenol | Alternaria sp. | [137] |
| (-)-(10E,15S)-10(11)–dehydrocurvularin, (-)-(10E,15S)-6-Chloro-10(11)-dehydrocurvularin | Alternaria sp. AST0039 | [138] |
| Phomoxanthone A | P. longicolla | [139] |
| Embellicines A and B | E. eureka | [140] |
| Pyrrocidin A | N. ramulariae Wollenw KS-246 | [141] |
| Aphidicolin | N. sphaerica | [142] |
| Steroid (22E,24R)-8,14-epoxyergosta-4,22-diene-3,6-dione | P. immersa | [142] |
| 12′-Hydroxyroridin E, 13′,14′-hydroxymytoxin B, 14′- hydroxymytoxin B, vertisporin, mytoxin C, roridin E, 2’,3’-epoxymyrotecin A, myrothecin A, myrotoxin A | M. roridum | [143] |
| Daldinone I | Annulohypoxylon sp. | [144] |
| Cladosporol A | C. cladosporioides | [145] |
| Engyodontiumones H, AGI-B4 | E. album DFFSCS021 | [145] |
| Rosoloactone | T. roseum | [146] |
| Penipacide A and E | P. paneum | [147] |
| Beauvericin | Fusarium oxysporum EPH2RAA | [148] |
| Bikaverin | F. oxysporum CEC1S | [148] |
| Beauvericin | F. oxysporum | [149] |
| Penichryfurans A and B | P. chrysogenum | [150] |
| Brefeldin A (BFA) | P. brefeldianum | [151] |
| Porritoxin | A. porri | [152] |
| Amides (AI-77-B, AI-77-F, Sg17-1-4) | A. tenuis sg17-1 | [153] |
| Dehydroaltenusin | A. tenuis | [154] |
| Alternariol, alternariol 5-O-sulfate, alternariol 5-O-methyl ether, altenusin, desmethykaltenusin | Alternaria sp. | [154] |
| Alternol | A. alternata var. monosporus | [155] |
| Cajanol (5-hydroxy-3-(4-hydroxy-2-methoxyphenyl)-7-methoxychroman-4-one) | H. lixii | [156] |
| Sorbicillinoids and bisorbicillinoids | P. chrysogenum Penicillium sp. P. terrestre Phialocephala sp. S. album Trichoderma sp. Trichothecium sp. | [157,158,159,160,161,162,163,164,165,166,167,168] |
| Sorbicillinoids: tricoreeseione A and B, tricodermolide B, 13-hydroxytricodermolide, 24-hydroxy-tricodimerol, 15-hydroxybisvertinol Analogs of sorbicillinoids: trichodimerol, 24-hydroxy-bisvertinol, bisvertinol | T. reesei HN-2016-018 | [169] |
| Deacetylcytophasin C, zygosporin D | C. taii | [170] |
| Ylarone A, (-)5-methylmelein | X. psidii | [171] |
| Diapolic acid AB, xylarolide, fomolide | D. terebinthifolli | [172] |
| Pestalrone B | P. karstenii | [173] |
| Siccayne [2-(3-methyl-3-buten-1-ynyl) hydro] | P. fici | [173] |
| Chaetoglobosins A, B, D, E, F, Fex, 20-dihydrochaetoglobosin A | C. globosum | [174,175] |
| Pensulfonoxy, Pensulfonamide | P. aculeatum | [176] |
| Polonidine A, fructigenine A | P. polonicum TY12 | [177] |
| Giluterrin | A. terreus P63 | [178] |
| Arvoredol | Penicillium sp. F37 | [179] |
| Anhydrofusarubin, fusarubin | Cladosporium sp. | [180] |
| Xanthocillins X and Y1 | P. chrysogenum CCTCC M 2020019 | [181] |
6.2. Antimicrobial Compounds
6.3. Cytotoxic and Antimicrobial Compounds Produced by Extremophile Fungi
| Metabolites | Fungi Species | References |
|---|---|---|
| Xanthocillins X (cytotoxicity and antimicrobial) and Y1 (antimicrobial) | P. chrysogenum CCTCC M 2020019 | [181] |
| Monocerin and annularin I (antimicrobial) | E. rostratum | [209,210] |
| Emericellipsin A (cytotoxicity) | E. alkalina | [229] |
| Versicolorin C and versiconol (cytotoxicity) | Aspergillus sp. SDC28 | [234] |
7. General Considerations
8. Conclusions
Funding
Acknowledgments
Conflicts of Interest
References
- Newman, D.J.; Cragg, G.M. Natural products as sources of new drugs over the nearly four decades from 01/1981 to 09/2019. J. Nat. Prod. 2020, 83, 770–803. [Google Scholar] [CrossRef] [PubMed]
- Newman, D.J.; Cragg, G.M. Plant endophytes and epiphytes: Burgeoning sources of known and ʺunknownʺ cytotoxic and antibiotic agents? Planta Med. 2020, 86, 891–905. [Google Scholar] [CrossRef] [PubMed]
- Přichystal, J.; Schug, K.A.; Lemr, K.; Novák, J.; Havlíček, V. Structural analysis of natural products. Anal. Chem. 2016, 88, 10338–10346. [Google Scholar] [CrossRef] [PubMed]
- Gakuubi, M.M.; Munusamy, M.; Liang, Z.-X.; Ng, S.B. Fungal endophytes: A promising frontier for discovery of novel bioactive compounds. J. Fungi 2021, 7, 786. [Google Scholar] [CrossRef] [PubMed]
- Hridoy, M.; Gorapi, M.Z.H.; Noor, S.; Chowdhury, N.S.; Rahman, M.M.; Muscari, I.; Masia, F.; Adorisio, S.; Delfino, D.V.; Mazid, M.A. Putative anticancer compounds from plant-derived endophytic fungi: A review. Molecules 2022, 27, 296. [Google Scholar] [CrossRef] [PubMed]
- Ancheeva, E.; Daletos, G.; Proksch, P. Bioactive secondary metabolites from endophytic fungi. Curr. Med. Chem. 2020, 27, 1836–1854. [Google Scholar] [CrossRef]
- Xu, K.; Wei, X.L.; Xue, L.; Zhang, Z.F.; Zhang, P. Antimicrobial meroterpenoids and erythritol derivatives isolated from the marine-algal-derived endophytic fungus Penicillium chrysogenum XNM-12. Mar. Drugs 2020, 18, 578. [Google Scholar] [CrossRef]
- Meena, H.; Hnamte, S.; Siddhardha, B. Secondary metabolites from endophytic fungi: Chemical diversity and application. In Advances in Endophytic Fungal Research; Singh, B., Ed.; Fungal Biology; Springer: Cham, Switzerland, 2019; Volume 1, pp. 145–169. [Google Scholar] [CrossRef]
- Soares, D.A.; Rosa, L.H.; Silva, J.M.F.; Pimenta, R.S. A review of bioactive compounds produced by endophytic fungi associated with medicinal plants. Bol. Mus. Para. Emílio Goeldi Cienc. Nat. 2017, 12, 331–352. [Google Scholar] [CrossRef]
- Nisa, H.; Kamili, A.N.; Nawchoo, I.A.; Shafi, S.; Shameem, N.; Bandh, S.A. Fungal endophytes as prolific source of phytochemicals and other bioactive natural products: A review. Microb. Pathog. 2015, 82, 50–59. [Google Scholar] [CrossRef]
- Kim, C.K.; Eo, J.K.; Eom, A.H. Diversity and seasonal variation of endophytic fungi isolated from three conifers in Mt. Taehwa, Korea. Mycobiology 2013, 41, 82–85. [Google Scholar] [CrossRef]
- Swamy, M.K.; Tuyelee, D.; Nandy, S.; Mukherjee, A.; Pandey, D.K.; Dey, A. Endophytes for the production of anticancer drug, paclitaxel. In Paclitaxel: Sources, Chemistry, Anticancer Actions, and Current Biotechnology; Swamy, M.K., Pullaiah, T., Chen, Z.-S., Eds.; Academic Press: Cambridge, MA, USA, 2022; pp. 203–228. [Google Scholar] [CrossRef]
- Brakhage, A.A.; Schroeckh, V. Fungal secondary metabolites—Strategies to activate silent gene clusters. Fungal Genet. Biol. 2010, 48, 15–22. [Google Scholar] [CrossRef]
- Pfannenstiel, R.T.; Keller, N.P. On top of biosynthetic gene clusters: How epigenetic machinery influences secondary metabolism in fungi. Biotechnol. Adv. 2019, 37, 107345. [Google Scholar] [CrossRef]
- Bills, G.F.; Gloer, J.B. Biologically active secondary metabolites from the fungi. Microbiol. Spect. 2016, 4, FUNK-0009-2016. [Google Scholar] [CrossRef]
- Bérdy, J. Thoughts and facts about antibiotics: Where we are now and where we are heading. J. Antibiot. 2012, 65, 385–395. [Google Scholar] [CrossRef]
- Nett, M.; Ikeda, H.; Moore, B.S. Genomic basis for natural product biosynthetic diversity in the actinomycetes. Nat. Prod. Rep. 2009, 26, 1362–1384. [Google Scholar] [CrossRef]
- Srivastava, N.; Srivastava, M.; Ramteke, P.W.; Mishra, P.K. Solid-state fermentation strategy for microbial metabolites production: An overview. In New and Future Developments in Microbial Biotechnology and Bioengineering; Gupta, V.J., Pandey, A., Eds.; Elsevier: Amsterdam, The Netherlands, 2019; Volume 1, pp. 345–354. [Google Scholar] [CrossRef]
- Mulder, K.C.; Mulinari, F.; Franco, O.L.; Soares, M.S.; Magalhães, B.S.; Parachin, N.S. Lovastatin production: From molecular basis to industrial process optimization. Biotechnol. Adv. 2015, 1, 648–665. [Google Scholar] [CrossRef]
- Zahari, N.A.A.R.; Chong, G.H.; Abdullah, L.C.; Chua, B.L. Ultrasonic-assisted extraction (UAE) process on thymol concentration from Plectranthus Amboinicus leaves: Kinetic modeling and optimization. Processes 2020, 8, 322. [Google Scholar] [CrossRef]
- Mai, P.-Y.; Le Goff, G.; Poupon, E.; Lopes, P.; Moppert, X.; Costa, B.; Beniddir, M.A.; Ouazzani, J. Solid-Phase extraction embedded dialysis (speed), an innovative procedure for the investigation of microbial specialized metabolites. Mar. Drugs 2021, 19, 371. [Google Scholar] [CrossRef]
- Wolfender, J.-L.; Litaudon, M.; Touboul, D.; Queiroz, E.F. Innovative omics-based approaches for prioritisation and targeted isolation of natural products—new strategies for drug discovery. Nat. Prod. Rep. 2019, 36, 855–868. [Google Scholar] [CrossRef]
- Fox Ramos, A.E.; Evanno, L.; Poupon, E.; Champy, P.; Beniddir, M.A. Natural products targeting strategies involving molecular networking: Different manners, one goal. Nat. Prod. Rep. 2019, 36, 960–980. [Google Scholar] [CrossRef]
- Grkovic, T.; Pouwer, R.H.; Vial, M.-L.; Gambini, L.; Noel, A.; Hooper, J.N.A.; Wood, S.A.; Mellick, G.D.; Quinn, R.J. NMR fingerprints of the drug-like natural-product space identify Iotrochotazine A: A chemical probe to study parkinson’s disease. Angew. Chem. Int. Ed. 2014, 53, 6070–6074. [Google Scholar] [CrossRef] [PubMed]
- Lang, G.; Mayhudin, N.A.; Mitova, M.I.; Sun, L.; Van der Sar, S.; Blunt, J.W.; Cole, A.L.J.; Ellis, G.; Laatsch, H.; Munro, M.H.G. Evolving trends in the dereplication of natural product extracts: New methodology for rapid, small-scale investigation of natural product extracts. J. Nat. Prod. 2008, 71, 1595–1599. [Google Scholar] [CrossRef] [PubMed]
- Zhang, C.; Idelbayev, Y.; Roberts, N.; Tao, Y.; Nannapaneni, Y.; Duggan, B.M.; Min, J.; Lin, E.C.; Gerwick, E.C.; Cottrell, G.W.; et al. Small molecule accurate recognition technology (SMART) to enhance natural products research. Sci. Rep. 2017, 7, 14243. [Google Scholar] [CrossRef] [PubMed]
- Wang, M.; Carver, J.J.; Phelan, V.V.; Sanchez, L.M.; Garg, N.; Peng, Y.; Nguyen, D.D.; Watrous, J.; Kapono, C.A.; Luzzatto-Knaan, T.; et al. Sharing and community curation of mass spectrometry data with Global Natural Products Social Molecular Networking. Nat. Biotechnol. 2016, 34, 828–837. [Google Scholar] [CrossRef] [PubMed]
- Ho, C.S.; Lam, C.W.K.; Chan, M.H.M.; Cheung, R.C.K.; Law, L.K.; Lit, L.C.W.; Ng, K.F.; Suen, M.W.M.; Tai, H.L. Electrospray ionisation mass spectrometry: Principles and clinical applications. Clin. Biochem. Rev. 2003, 24, 3–12. [Google Scholar]
- Grkovic, T.; Akee, R.K.; Thornburg, C.C.; Spencer, K.; Trinh, S.K.; Britt, J.R.; Harris, M.J.; Evans, J.R.; Kang, U.; Ensel, S.; et al. National Cancer Institute (NCI) Program for Natural Products Discovery: Rapid isolation and identification of biologically active natural products from the nci prefractionated library. ACS Chem. Biol. 2020, 15, 1104–1114. [Google Scholar] [CrossRef]
- Tsao, R.; Yang, R.; Young, J.C.; Zhu, H. Polyphenolic profiles in eight apple cultivars using high-performance liquid chromatography (HPLC). J. Agric. Food Chem. 2003, 51, 6347–6353. [Google Scholar] [CrossRef]
- Aguilar, M.I. Reversed-phase high-performance liquid chromatography. In HPLC of Peptides and Proteins; Methods in Molecular Biology; Springer: Totowa, NJ, USA, 2004; p. 251. [Google Scholar] [CrossRef]
- Câmara, J.S.; Martins, C.; Pereira, J.A.M.; Perestrelo, R.; Rocha, S.M. Chromatographic-based platforms as new avenues for scientific progress and sustainability. Molecules 2022, 27, 5267. [Google Scholar] [CrossRef]
- Coates, J. Interpretation of Infrared Spectra, A Practical Approach. In Encyclopedia of Analytical Chemistry; John Wiley & Sons, Ltd.: Chichester, UK, 2006; pp. 1–23. [Google Scholar] [CrossRef]
- Nagarajan, K.; Ibrahim, B.; Ahmad Bawadikji, A.; Lim, J.-W.; Tong, W.-Y.; Leong, C.-R.; Khaw, K.Y.; Tan, W.-N. Recent developments in metabolomics studies of endophytic fungi. J. Fungi 2022, 8, 28. [Google Scholar] [CrossRef]
- Krishnan, V.V.; Rupp, B. Macromolecular structure determination: Comparison of X-ray crystallography and NMR spectroscopy. In eLS; John Wiley & Sons: Hoboken, NJ, USA, 2012. [Google Scholar] [CrossRef]
- Zloh, M. NMR spectroscopy in drug discovery and development: Evaluation of physico-chemical properties. ADMET DMPK 2019, 7, 242–251. [Google Scholar] [CrossRef]
- Emwas, A.-H.; Roy, R.; McKay, R.T.; Tenori, L.; Saccenti, E.; Gowda, G.A.N.; Raftery, D.; Alahmari, F.; Jaremko, L.; Jaremko, M. NMR spectroscopy for metabolomics research. Metabolites 2019, 9, 123. [Google Scholar] [CrossRef]
- Bartle, K.D.; Myers, P. History of gas chromatography. TrAC—Trends Analyt. Chem. 2002, 21, 547–557. [Google Scholar] [CrossRef]
- Zapata, L.S.; Tabarez, M.R.; Alvarez, J.C.; Escobar, V.V. Reviewing microbial behaviors in ecosystems leading to a natural quorum quenching occurrence. Biological and applied sciences. Braz. Arch. Biol. Technol. 2017, 60, 1–12. [Google Scholar] [CrossRef][Green Version]
- Schulz, S.; Dickschat, J.S. Bacterial volatiles: The smell of small organisms. Nat. Prod. Rep. 2007, 24, 814–842. [Google Scholar] [CrossRef]
- Singh, B.N.; Prateeksha, U.D.K.; Singh, B.R.; Defoirdt, T.; Gupta, V.K.; de Souza, A.O.; Singh, H.B.; Barreira, J.C.; Ferreira, I.C.; Vahabi, K. Bactericidal, quorum quenching and anti-biofilm nanofactories: A new niche for nanotechnologists. Crit. Rev. Biotechnol. 2017, 37, 525–540. [Google Scholar] [CrossRef]
- Hogan, D.A. Talking to themselves: Autoregulation and quorum sensing in fungi. Eukaryot. Cell 2006, 5, 613–619. [Google Scholar] [CrossRef]
- Frisvad, J.C.; Andersen, B.; Thrane, U. The use of secondary metabolite profiling in chemotaxonomy of filamentous fungi. Mycol. Res. 2008, 112, 231–240. [Google Scholar] [CrossRef]
- Cottier, F.; Mühlschlegel, F.A. Communication in fungi. Int. J. Microbiol. 2011, 2012, 351832. [Google Scholar] [CrossRef]
- Albuquerque, P.; Casadevall, A. Quorum sensing in fungi—A review. Med. Mycol. 2012, 50, 337–345. [Google Scholar] [CrossRef]
- Polke, M.; Hube, B.; Jacobsen, I.D. Candida survival strategies. Adv. Appl. Microbiol. 2015, 91, 139–235. [Google Scholar] [CrossRef]
- Nemcovic, M.; Jakubíková, L.; Víden, I.; Farkas, V. Induction of conidiation by endogenous volatile compounds in Trichoderma spp. FEMS Microbiol. Lett. 2008, 284, 231–236. [Google Scholar] [CrossRef] [PubMed]
- Chitarra, G.S.; Abee, T.; Rombouts, F.M.; Dijksterhuis, J. 1-Octen-3-ol inhibits conidia germination of Penicillium paneum despite of mild effects on membrane permeability, respiration, intracellular pH, and changes the protein composition. FEMS Microbiol. Ecol. 2005, 54, 67–75. [Google Scholar] [CrossRef] [PubMed]
- Elmassry, M.M.; Farag, M.A.; Preissner, R.; Gohlke, B.O.; Piechulla, B.; Lemfack, M.C. Sixty-one volatiles have phylogenetic signals across bacterial domain and fungal kingdom. Front. Microbiol. 2020, 11, 557253. [Google Scholar] [CrossRef] [PubMed]
- Hornby, J.M.; Jensen, E.C.; Lisec, A.D.; Tasto, J.J.; Jahnke, B.; Shoemaker, R.; Dussault, P.; Nickerson, K.W. Quorum sensing in the dimorphic fungus Candida albicans is mediated by farnesol. Appl. Environ. Microbiol. 2001, 67, 2982–2992. [Google Scholar] [CrossRef] [PubMed]
- Kruppa, M. Quorum sensing and Candida albicans. Mycoses 2009, 52, 1–10. [Google Scholar] [CrossRef]
- Weber, K.; Schulz, B.; Ruhnke, M. The quorum-sensing molecule E,E-farnesol—its variable secretion and its impact on the growth and metabolism of Candida species. Yeast 2010, 27, 727–739. [Google Scholar] [CrossRef]
- Sprague, G.F.; Winans, S.C. Eukaryotes learn how to count: Quorum sensing by yeast. Genes Dev. 2006, 20, 1045–1049. [Google Scholar] [CrossRef]
- Bassler, B.L. How bacteria talk to each other: Regulation of gene expression by quorum sensing. Curr. Opin. Microbiol. 1999, 2, 582–587. [Google Scholar] [CrossRef]
- Rasmussen, T.B.; Skindersoe, M.E.; Bjarnsholt, T.; Phipps, R.K.; Christensen, K.B.; Jensen, P.O.; Andersen, J.B.; Koch, B.; Larsen, T.O.; Hentzer, M.; et al. Identity and effects of quorum-sensing inhibitors produced by Penicillium species. Microbiology 2005, 151, 1325–1340. [Google Scholar] [CrossRef]
- Padder, S.A.; Prasad, R.; Shah, A.H. Quorum sensing: A less known mode of communication among fungi. Microbiol. Res. 2018, 210, 51–58. [Google Scholar] [CrossRef]
- Lemfack, M.C.; Nickel, J.; Dunkel, M.; Preissner, R.; Piechulla, B. mVOC: A database of microbial volatiles. Nucleic Acids Res. 2014, 42, 744–748. [Google Scholar] [CrossRef]
- Lemfack, M.C.; Gohlke, B.-O.; Toguem, S.M.T.; Preissner, S.; Piechulla, B.; Preissner, R. mVOC 2.0: A database of microbial volatiles. Nucleic Acids Res. 2018, 46, 1261–1265. [Google Scholar] [CrossRef]
- Microbial Volatile Organic Compound Database. Available online: https://bioinformatics.charite.de/mvoc/index.php?site=home (accessed on 6 November 2022).
- Mishra, S.; Sahu, P.K.; Agarwal, V.; Singh, N. Exploiting endophytic microbes as micro-factories for plant secondary metabolite production. Appl. Microbiol. Biotechnol. 2021, 105, 6579–6596. [Google Scholar] [CrossRef]
- Vinaixa, M.; Schymanski, E.L.; Neumann, S.; Navarro, M.; Salek, R.M.; Yanes, O. Mass spectral databases for LC/MS- and GC/MS-based metabolomics: State of the field and future prospects. Trends Anal. Chem. 2016, 78, 23–35. [Google Scholar] [CrossRef]
- Harvey, A.L.; Edrada-Ebel, R.; Quinn, R.J. The reemergence of natural products for drug discovery in the genomics era. Nat. Rev. Drug Discov. 2015, 14, 111–129. [Google Scholar] [CrossRef]
- Thornburg, C.C.; Britt, J.R.; Evans, J.R.; Akee, R.K.; Whitt, J.A.; Trinh, S.K.; Harris, M.J.; Thompson, J.R.; Ewing, T.L.; Shipley, S.M. NCI program for natural product discovery: A publicly-accessible library of natural product fractions for high-throughput screening. ACS Chem. Biol. 2018, 13, 2484–2497. [Google Scholar] [CrossRef]
- Herrmann, K.M.; Weaver, L.M. The shikimate pathway. Annu. Rev. Plant Physiol. Plant Mol. Biol. 1999, 50, 473–503. [Google Scholar] [CrossRef]
- Keller, N.P. Fungal secondary metabolism: Regulation, function and drug discovery. Nat. Rev. Microbiol. 2018, 17, 167–180. [Google Scholar] [CrossRef]
- Nielsen, J.C.; Prigent, S.; Grijseels, S.; Workman, M.; Ji, B.; Nielsen, J. Comparative transcriptome analysis shows conserved metabolic regulation during production of secondary metabolites in filamentous fungi. mSystems 2019, 4, e00012-19. [Google Scholar] [CrossRef]
- El Hajj Assaf, C.; Zetina-Serrano, C.; Tahtah, N.; Khoury, A.E.; Atoui, A.; Oswald, I.P.; Puel, O.; Lorber, S. Regulation of secondary metabolism in the Penicillium Genus. Int. J. Mol. Sci. 2020, 21, 9462. [Google Scholar] [CrossRef]
- Deepika, V.B.; Murali, T.S.; Satyamoorthy, K. Modulation of genetic clusters for synthesis of bioactive molecules in fungal endophytes: A review. Microbiol. Res. 2016, 182, 125–140. [Google Scholar] [CrossRef] [PubMed]
- Liou, G.F.; Khosla, C. Building-block selectivity of polyketide synthases. Curr. Opin. Chem. Biol. 2003, 7, 279–284. [Google Scholar] [CrossRef]
- Weissman, K.J. Introduction to polyketide biosynthesis. Methods Enzymol. 2009, 459, 3–16. [Google Scholar] [CrossRef] [PubMed]
- Qadri, M. Polyketides: Bioactive Secondary Metabolites, Biosynthesis, and Their Modulation. In Endophyte Biology: Recent Findings from the Kashmir Himalayas, 1st ed.; Zahoor, A.W., Masroor, Q., Palak, A., Khalid, R.H., Eds.; Apple Academic Press: New York, NY, USA, 2022; pp. 1–346. [Google Scholar] [CrossRef]
- Cox, R.; Skellam, E.; Williams, K. Biosynthesis of fungal polyketides. In The Mycota: Physiology and Genetics, 2nd ed.; Anke, T., Schüffler, A., Eds.; Springer: Cham, Switzerland, 2018; Volume 15, pp. 385–412. [Google Scholar] [CrossRef]
- Cox, R.J.; Simpson, T.J. Fungal type I polyketide synthases. Methods Enzymol. 2009, 459, 49–78. [Google Scholar] [CrossRef] [PubMed]
- Fujii, I. Functional analysis of fungal polyketide biosynthesis genes. J. Antibiot. Res. 2010, 63, 207–218. [Google Scholar] [CrossRef]
- Martínez-Núñez, M.A.; López, V.E.L.Y. Nonribosomal peptides synthetases and their applications in industry. Sustain. Chem. Process. 2016, 13, 1–8. [Google Scholar] [CrossRef]
- Martín, J.F.; García-Estrada, C.; Zeilinger, S. Biosynthesis and Molecular Genetics of Fungal Secondary Metabolites, 1st ed.; Fungal Biology; Springer: New York, NY, USA, 2014; pp. 1–351. [Google Scholar] [CrossRef]
- Zhang, L.; Wang, C.; Chen, K.; Zhong, W.; Xu, Y.; Molnár, I. Engineering the biosynthesis of fungal nonribosomal peptides. Nat. Prod. Rep, 2022; Ahead of print. [Google Scholar] [CrossRef]
- Bills, G.; Li, Y.; Chen, L.; Yue, Q.; Niu, X.M.; An, Z. New insights into the echinocandins and other fungal non-ribosomal peptides and peptaibiotics. Nat. Prod. Rep. 2014, 31, 1348–1375. [Google Scholar] [CrossRef]
- Qiao, K.; Zhou, H.; Xu, W.; Zhang, W.; Garg, N.; Tang, Y. A fungal nonribosomal peptide synthetase module that can synthesize thiopyrazines. Org. Lett. 2011, 13, 1758–1761. [Google Scholar] [CrossRef]
- Cao, L.; Do, T.; Link, A.J. Mechanisms of action of ribosomally synthesized and posttranslationally modified peptides (RiPPs). J. Ind. Microbiol. Biotechnol. 2021, 48, kuab005. [Google Scholar] [CrossRef]
- Arnison, P.G.; Bibb, M.J.; Bierbaum, G.; Bowers, A.A.; Bugni, T.S.; Bulaj, G.; Julio, A.C.; Dominic, J.C.; Gregory, L.C.; Jon, C. Ribosomally synthesized and post-translationally modified peptide natural products: Overview and recommendations for a universal nomenclature. Nat. Prod. Rep. 2013, 30, 108–160. [Google Scholar] [CrossRef]
- Fu, Y.; Jaarsma, A.H.; Kuipers, O.P. Antiviral activities and applications of ribosomally synthesized and post-translationally modified peptides (RiPPs). Cell. Mol. Life Sci. 2021, 78, 3921–3940. [Google Scholar] [CrossRef]
- Wu, C.; van der Donk, W.A. Engineering of new-to-nature ribosomally synthesized and post-translationally modified peptide natural products. Curr. Opin. Chem. Biol. 2021, 69, 221–231. [Google Scholar] [CrossRef]
- Hetrick, K.J.; van der Donk, W.A. Ribosomally synthesized and post-translationally modified peptide natural product discovery in the genomic era. Curr. Opin. Chem. Biol. 2017, 38, 36–44. [Google Scholar] [CrossRef]
- Yin, Z.; Dickschat, J.S. Engineering fungal terpene biosynthesis. Nat. Prod. Rep, 2022; Ahead of print. [Google Scholar] [CrossRef]
- Wawrzyn, G.T.; Bloch, S.E.; Schmidt-Dannert, C. Discovery and characterization of terpenoid biosynthetic pathways of fungi. Meth. Enzymol. 2012, 515, 83–105. [Google Scholar] [CrossRef]
- Schüller, A.; Wolansky, L.; Berger, H.; Studt, L.; Gacek-Matthews, A.; Sulyok, M.; Strauss, J. A novel fungal gene regulation system based on inducible VPR-dCas9 and nucleosome map-guided sgRNA positioning. Appl. Microbiol. Biotechnol. 2020, 104, 9801–9822. [Google Scholar] [CrossRef]
- Goers, L.; Freemont, P.; Polizzi, K.M. Co-culture systems and technologies: Taking synthetic biology to the next level. J. R. Soc. Interface 2014, 11, 20140065. [Google Scholar] [CrossRef]
- Fleming, A. On the antibacterial action of cultures of a Penicillium, with special reference to their use in the isolation of B. influenza. Br. J. Exp. Pathol. 1929, 10, 226–236. [Google Scholar] [CrossRef]
- Houbraken, J.; Frisvad, J.C.; Samson, R.A. Fleming’s penicillin producing strain is not Penicillium chrysogenum but P. rubens. IMA Fungus 2011, 2, 87–95. [Google Scholar] [CrossRef]
- Patel, G.; Patil, M.D.; Soni, S.; Chisti, Y.; Banerjee, U.C. Production of mycophenolic acid by Penicillium brevicompactum using solid state fermentation. Appl. Biochem. Biotechnol. 2017, 182, 97–109. [Google Scholar] [CrossRef]
- Godtfredsen, W.O.; Jahnsen, S.; Lorck, H.; Roholt, K.; Tybring, L. Fusidic acid: A new antibiotic. Nature 1962, 4819, 987. [Google Scholar] [CrossRef]
- Fernandes, P. Fusidic acid: A bacterial elongation factor inhibitor for the oral treatment of acute and chronic staphylococcal infections. Cold Spring Harb. Perspect. Med. 2016, 6, a025437. [Google Scholar] [CrossRef] [PubMed]
- Ni, J.; Guo, M.; Cao, Y.; Lei, L.; Liu, K.; Wang, B.; Lu, F.; Zhai, R.; Gao, X.; Yan, C.; et al. Discovery, synthesis of novel fusidic acid derivatives possessed amino-terminal groups at the 3-hydroxyl position with anticancer activity. Eur. J. Med. Chem. 2019, 162, 122–131. [Google Scholar] [CrossRef] [PubMed]
- Hu, D.; Gao, H.; Yao, X.S. Biosynthesis of triterpenoid natural products. In Comprehensive Natural Products III, 3rd ed.; Hung-Wen, B.L., Tadhg, P.B., Eds.; Elsevier: Alpharetta, GA, USA, 2020; pp. 1–37. [Google Scholar]
- Koble, H.; Traber, R. Directed biosynthesis of cyclosporins. Eur. J. Appl. Microbiol. Biotechnol. 1982, 14, 237–240. [Google Scholar] [CrossRef]
- Agathos, S.N.; Parekh, R. Enhancement of cyclosporin production in a Tolypocladium inflatum strain after epichlorohydrin treatment. J. Biotechnol. 1990, 13, 73–81. [Google Scholar] [CrossRef]
- Petersen, A.B.; Rønnest, M.H.; Larsen, T.O.; Clausen, M.H. The chemistry of griseofulvin. Chem. Rev. 2014, 114, 12088–12107. [Google Scholar] [CrossRef] [PubMed]
- Desjardins, A.E.; Manandhar, H.K.; Plattner, R.D.; Manandhar, G.G.; Poling, S.M.; Maragos, C.M. Fusarium species from Nepalese rice and production of mycotoxins and gibberellic acid by selected species. Microbiol. Appl. Environ. 2000, 66, 1020–1025. [Google Scholar] [CrossRef]
- Bailey, A.M.; Alberti, F.; Kilaru, S.; Collins, C.M.; de Mattos-Shipley, K.; Hartley, A.J.; Hayes, P.; Griffin, A.; Lazarus, C.M.; Cox, R.J.; et al. Identification and manipulation of the pleuromutilin gene cluster from Clitopilus passeckerianus for increased rapid antibiotic production. Sci. Rep. 2016, 6, 25202. [Google Scholar] [CrossRef]
- Balba, H. Review of strobilurin fungicide chemicals. J. Environ. Sci. Health B 2007, 42, 441–451. [Google Scholar] [CrossRef]
- Chen, L.; Yue, Q.; Li, Y.; Niu, X.; Xiang, M.; Wang, W.; Bills, G.F.; Liu, X.; An, Z. Engineering of Glarea lozoyensis for exclusive production of the pneumocandin B0 precursor of the antifungal drug caspofungin acetate. Appl. Environ. Microbiol. 2015, 81, 1550–1558. [Google Scholar] [CrossRef]
- Men, P.; Wang, M.; Li, J.; Geng, C.; Huang, X.; Lu, X. Establishing an efficient genetic manipulation system for sulfated echinocandin producing fungus Coleophoma empetri. Front. Microbiol. 2021, 12, 734780. [Google Scholar] [CrossRef]
- Wei, T.-Y.; Zheng, Y.; Wan, M.; Yang, S.; Tang, J.; Wu, Y.; Li, J.; Chen, S.-X. Analysis of FR901379 biosynthetic genes in Coleophoma empetri by CRISPR/Cas9-based genomic manipulation. ACS Chem. Biol. 2022, 17, 8–2130. [Google Scholar] [CrossRef]
- Norris, T.; VanAlsten, J.; Hubbs, S.; Ewing, M.; Cai, W.; Bordner, J.; Jensen, O.G. Commercialization and Late-Stage Development of a Semisynthetic Antifungal API: Anidulafungin/d-Fructose (Eraxis). Org. Process Res. Dev. 2008, 12, 447–455. [Google Scholar] [CrossRef]
- Peláez, F.; Cabello, A.; Platas, G.; Díez, M.T.; Del Val, A.G.; Basilio, A.; Martán, I.; Vicente, F.; Bills, G.E.; Giacobbe, R.A.; et al. The discovery of enfumafungin, a novel antifungal compound produced by an endophytic Hormonema species biological activity and taxonomy of the producing organisms. Syst. Appl. Microbiol. 2000, 23, 333–343. [Google Scholar] [CrossRef]
- Apgar, J.M.; Wilkening, R.R.; Parker, D.L., Jr.; Meng, D.; Wildonger, K.J.; Sperbeck, D.; Greenlee, M.L.; Balkovec, J.M.; Flattery, A.M.; Abruzzo, G.K.; et al. Ibrexafungerp: An orally active beta-1,3-glucan synthesis inhibitor. Bioorg. Med. Chem. Lett. 2020, 32, 127661. [Google Scholar] [CrossRef]
- Xie, L.G.; Zhu, G.D.; Shang, J.J.; Chen, X.M.; Zhang, C.T.; Ji, X.L.; Zhang, Q.; Wei, Y.L. An overview on the biological activity and anti-cancer mechanism of lovastatin. Cell Signal. 2021, 87, 110122. [Google Scholar] [CrossRef]
- Baba, S.; Abe, Y.; Suzuki, T.; Ono, C.; Iwamoto, K.; Nihira, T.; Hosobuchi, M. Improvement of compactin (ML-236B) production by genetic engineering in compactin high-producing Penicillium citrinum. Appl. Microbiol. Biotechnol. 2009, 83, 697–704. [Google Scholar] [CrossRef]
- Fujita, T.; Matsumoto, N.; Uchida, S.; Kohno, T.; Shimizu, T.; Hirose, R.; Yanada, K.; Kurio, W.; Watabe, K. Antibody against a novel, myriocin (ISP-I)-based immunosuppressant, FTY720. Bioorg. Med. Chem. Lett. 2000, 10, 337–339. [Google Scholar] [CrossRef]
- Guruceaga, X.; Perez-Cuesta, U.; Abad-Diaz de Cerio, A.; Gonzalez, O.; Alonso, R.M.; Hernando, F.L.; Ramirez-Garcia, A.; Rementeria, A. Fumagillin, a mycotoxin of Aspergillus fumigatus: Biosynthesis, biological activities, detection, and applications. Toxins 2019, 12, 7. [Google Scholar] [CrossRef]
- Amici, A.M.; Minghetti, A.; Scotti, T.; Spalla, C.; Tognoli, L. Production of ergotamine by a strain of Claviceps purpurea (Fr.) Tul. Experientia 1966, 22, 415–416. [Google Scholar] [CrossRef]
- Meneghetti, F.; Ferraboschi, P.; Grisenti, P.; Reza, E.S.; Mori, M.; Ciceri, S. Crystallographic and NMR investigation of ergometrine and methylergometrine, two alkaloids from Claviceps purpurea. Molecules 2020, 25, 331. [Google Scholar] [CrossRef]
- Amici, A.M.; Minghetti, A.; Scotti, T.; Spalla, C.; Tognoli, L. Production of peptide ergot alkaloids in submerged culture by three isolates of Claviceps purpurea. Microbiol. Appl. 1969, 18, 464–468. [Google Scholar] [CrossRef]
- Kawasaki, Y. Mizoribine: A new approach in the treatment of renal disease. Clin. Dev. Immunol. 2009, 2009, 681482. [Google Scholar] [CrossRef] [PubMed]
- Chen, J.; Arioka, M. Autophagy deficiency boosts the production of kojic acid in the filamentous fungus Aspergillus oryzae. Biosci. Biotechnol. Biochem. 2021, 85, 2429–2433. [Google Scholar] [CrossRef] [PubMed]
- Krücken, J.; Harder, A.; Jeschke, P.; Holden-Dye, L.; O’Connor, V.; Welz, C.; Von Samson-Himmelstjerna, G. Anthelmintic cyclcooctadepsipeptides: Complex in structure and mode of action. Trends Parasitol. 2012, 28, 385–394. [Google Scholar] [CrossRef] [PubMed]
- Kinkade, C.W.; Rivera-Núñez, Z.; Gorcyzca, L.; Aleksunes, L.M.; Barrett, E.S. Impact of fusarium-derived mycoestrogens on female reproduction: A systematic review. Toxins 2021, 13, 373. [Google Scholar] [CrossRef]
- Bray, F.; Laversanne, M.; Weiderpass, E.; Soerjomataram, I. The ever-increasing importance of cancer as a leading cause of premature death worldwide. Cancer 2021, 127, 3029–3030. [Google Scholar] [CrossRef]
- World Health Organization (WHO). Global Health Estimates 2020: Deaths by Cause, Age, Sex, by Country and by Region, 2000–2019; WHO: Geneva, Switzerland, 2020; Available online: https://www.who.int/health-topics/cancer#tab=tab_1 (accessed on 15 March 2022).
- Sung, H.; Ferlay, J.; Siegel, R.L.; Laversanne, M.; Soerjomataram, I.; Jemal, A.; Bray, F. Global Cancer Statistics 2020: GLOBOCAN estimates of incidence and mortality worldwide for 36 cancers in 185 countries. CA Cancer J. Clin. 2021, 71, 209–249. [Google Scholar] [CrossRef]
- INCA—Instituto Nacional do Câncer; Ministério da Saúde. Estatísticas de Câncer. Available online: https://www.inca.gov.br/numeros-de-cancer (accessed on 17 March 2022).
- Somarelli, J.A.; Boddy, A.M.; Gardner, H.L.; DeWitt, S.B.; Tuohy, J.; Megquier, K.; Sheth, M.U.; Hsu, S.D.; Thorne, J.L.; London, C.A.; et al. Improving cancer drug discovery by studying cancer across the tree of life. Mol. Biol. Evol. 2020, 37, 11–17. [Google Scholar] [CrossRef]
- Balde, E.S.; Andolfi, A.; Bruyère, C.; Cimmino, A.; Lamoral-Theys, D.; Vurro, M.; Damme, M.V.; Altomare, C.; Mathieu, V.; Kiss, R.; et al. Investigations of fungal secondary metabolites with potential anticancer activity. J. Nat. Prod. 2010, 73, 969–971. [Google Scholar] [CrossRef]
- Strobel, G. The emergence of endophytic microbes and their biological promise. J. Fungi 2018, 4, 57. [Google Scholar] [CrossRef]
- Chesnoff, S. The use of taxol as a trademark. Nature 1995, 374, 208. [Google Scholar] [CrossRef]
- Sykłowska-Baranek, K.; Sygitowicz, G.; Maciejak-Jastrz˛ebska, A.; Pietrosiuk, A.; Szakiel, A. Application of priming strategy for enhanced paclitaxel biosynthesis in Taxus x media hairy root cultures. Cells 2022, 11, 2062. [Google Scholar] [CrossRef]
- Stierle, A.; Strobel, G.; Stierle, D.D. Taxol and taxane production by Taxomyces andreanae, an endophytic fungus of Pacific yew. Science 1993, 260, 214–216. [Google Scholar] [CrossRef]
- Strobel, G.; Yang, X.; Sears, J.; Kramer, R.; Sidhu, R.S.; Hess, W.M.; Young, B. Taxol from Pestalotiopsis microspora, an endophytic fungus of Taxus wallachiana. Microbiology 1996, 142, 435–440. [Google Scholar] [CrossRef]
- Gangadevi, V.; Muthumary, J. Taxol, an anticancer drug produced by an endophytic fungus Bartalinia robillardoides Tassi, isolated from a medicinal plant, Aegle marmelos Correa ex Roxb. World J. Microbiol. Biotechnol. 2008, 24, 717–724. [Google Scholar] [CrossRef]
- Pandi, M.; Kumaran, R.S.; Choi, Y.; Kim, H.J.; Muthumary, J. Isolation and detection of taxol, an anticancer drug produced from Lasiodiplodia theobromae, an endophytic fungus of the medicinal plant Morinda citrifolia. Afr. J. Biotechnol. 2011, 10, 1428–1435. [Google Scholar] [CrossRef]
- Kumaran, R.S.; Kim, H.J.; Hur, B.K. Taxol promising fungal endophyte, Pestalotiopsis species isolated from Taxus cuspidata. J. Biosci. Bioeng. 2010, 110, 541–546. [Google Scholar] [CrossRef]
- Soliman, S.S.M.; Raizada, M.N. Interactions between co-habitating fungi elicit synthesis of Taxol from an endophytic fungus in host Taxus plants. Front. Microbiol. 2013, 4, 1–14. [Google Scholar] [CrossRef]
- Palem, P.P.C.; Kuriakose, G.C.; Jayabaskaran, C. An Endophytic Fungus, Talaromyces Radicus, Isolated from Catharanthus roseus, Produces Vincristine and Vinblastine, Which Induce Apoptotic Cell Death. PLoS ONE 2015, 10, e0144476. [Google Scholar] [CrossRef]
- Xiao, J.; Zhang, Q.; Gao, Y.Q.; Tang, J.J.; Zhang, A.L.; Gao, J.M. Secondary metabolites from the endophytic Botryosphaeria dothidea of Melia azedarach and their antifungal, antibacterial, antioxidant, and cytotoxic activities. J. Agric. Food Chem. 2014, 62, 3584–3590. [Google Scholar] [CrossRef]
- Wang, Y.; Liu, H.X.; Chen, Y.C.; Sun, Z.H.; Li, H.H.; Li, S.N.; Yan, M.L.; Zhang, W.M. Two new metabolites from the endophytic fungus Alternaria sp. A744 derived from Morinda officinalis. Molecules 2017, 22, 765. [Google Scholar] [CrossRef] [PubMed]
- Zhao, D.L.; Wang, D.; Tian, X.Y.; Cao, F.; Li, Y.Q.; Zhang, C.S. Anti-phytopathogenic and cytotoxic activities of crude extracts and secondary metabolites of marine-derived fungi. Mar. Drugs 2018, 16, 36. [Google Scholar] [CrossRef] [PubMed]
- Bashyal, B.P.; Wijeratne, E.M.K.; Tillotson, J.; Arnold, A.E.; Chapman, E.; Gunatilaka, A.A.L. Chlorinated Dehydrocurvularins and Alterperylenepoxide A from Alternaria sp. AST0039, a Fungal Endophyte of Astragalus lentiginosus. J. Nat. Prod. 2017, 80, 427–433. [Google Scholar] [CrossRef] [PubMed]
- Rönsberg, D.; Debbab, A.; Mándi, A.; Vasylyeva, V.; Böhler, P.; Stork, B.; Engelke, L.; Hamacher, A.; Sawadogo, R.; Diederich, M.; et al. Pro-apoptotic and immunostimulatory tetrahydroxanthone dimers from the endophytic fungus Phomopsis longicolla. J. Org. Chem. 2013, 78, 12409–12425. [Google Scholar] [CrossRef] [PubMed]
- Ebrahim, W.; Aly, A.H.; Wray, V.; Mándi, A.; Teiten, M.H.; Gaascht, F.; Orlikova, B.; Kassack, M.U.; Lin, W.; Diederich, M.; et al. Embellicines A and B: Absolute configuration and NF-κB tran-scriptional inhibitory activity. J. Med. Chem. 2013, 56, 2991–2999. [Google Scholar] [CrossRef]
- Uesugi, S.; Fujisawa, N.; Yoshida, J.; Watanabe, M.; Dan, S.; Yamori, T.; Shiono, Y.; Kimura, K. Pyrrocidine A, a metabolite of endophytic fungi, has a potent apoptosis-inducing activity against HL60 cells through caspase activation via the Michael addition. J. Antibiot. 2016, 69, 133–140. [Google Scholar] [CrossRef]
- Gallo, M.B.C.; Falso, M.J.S.; Balem, F.; Menezes, D.; Rocha, N.; Balachandran, R.; Sturgeon, T.S.; Pupo, M.T.; Day, B.W. The anti-promyelocytic leukemia mode of action of two endophytic secondary metabolites unveiled by a proteomic approach. Planta Med. 2014, 80, 473–481. [Google Scholar] [CrossRef] [PubMed]
- Lin, T.; Wang, G.; Zhou, Y.; Zeng, D.; Liu, X.; Ding, R.; Jiang, X.; Zhu, D.; Shan, W.; Chen, H. Structure elucidation and biological activity of two new trichothecenes from an endophyte, Myrothecium roridum. J. Agric. Food Chem. 2014, 62, 5993–6000. [Google Scholar] [CrossRef] [PubMed]
- Liu, Y.; Stuhldreier, F.; Kurtán, T.; Mándi, A.; Arumugam, S.; Lin, W.; Stork, B.; Wesselborg, S.; Weber, H.; Henrich, B.; et al. Daldinone derivatives from the mangrove derived endophytic fungus Annulohypoxylon sp. RSC Adv. 2017, 7, 5381–5393. [Google Scholar] [CrossRef]
- Koul, M.; Kumar, A.; Deshidi, R.; Sharma, V.; Sinqh, R.D.; Sinqh, J.; Sharma, P.R.; Shah, B.A.; Jaqlan, S.; Sinqh, S. Cladosporol. A triggers apoptosis sensitivity by ROS-mediated autophagic flux in human breast cancer cells. BMC Cell Biol. 2017, 18, 26. [Google Scholar] [CrossRef] [PubMed]
- Zhou, L.; Qin, J.; Ma, L.; Li, H.; Li, L.; Ning, C.; Gao, W.; Yu, H.; Han, L. Rosoloactone: A natural diterpenoid inducing apoptosis in human cervical cancer cells through endoplasmic reticulum stress and mitochondrial damage. Biomed. Pharmacother. 2017, 95, 355–362. [Google Scholar] [CrossRef] [PubMed]
- Li, C.S.; Li, X.M.; Gao, S.S.; Lu, Y.H.; Wang, B.G. Cytotoxic anthranilic acid derivatives from deep sea sediment-derived fungus Penicillium paneum SD-44. Mar. Drugs 2013, 11, 3068–3076. [Google Scholar] [CrossRef] [PubMed]
- Zhan, J.; Burns, A.M.; Liu, M.X.; Faeth, S.H.; Gunatilaka, A.A.L. Search for cell motility and angiogenesis inhibitors with potential anticancer activity: Beauvericin and other constituents of two endophytic strains of Fusarium oxysporum. J. Nat. Prod. 2007, 70, 227–232. [Google Scholar] [CrossRef] [PubMed]
- Wang, Q.X.; Li, S.F.; Zhao, F.; Dai, H.Q.; Bao, L.; Ding, R.; Gao, H.; Zhang, L.X.; Wen, H.A.; Liu, H.W. Chemical constituents from endophytic fungus Fusarium oxysporum. Fitoterapia 2011, 82, 777–781. [Google Scholar] [CrossRef] [PubMed]
- Chen, J.; Huo, L.N.; Gao, Y.; Zhang, Y.L.; Chen, Y. Two new N-acetyl-glucosamine derivatives from the medical algae-derived endophytic fungus Penicillium chrysogenum. Nat. Prod. Res. 2022, 36, 3988–3991. [Google Scholar] [CrossRef]
- Paek, S.M. Recent Synthesis and Discovery of brefeldin A analogs. Mar. Drugs 2018, 16, 133. [Google Scholar] [CrossRef]
- Horiuchi, M.; Tokuda, H.; Ohnishi, K.; Yamashita, M.; Nishino, H.; Maoka, T. Porritoxins, metabolites of Alternaria porri, as anti-tumor-promoting active compounds. Nat. Prod. Res. 2006, 20, 161–166. [Google Scholar] [CrossRef]
- Huang, Y.F.; Li, L.H.; Tian, L.; Qiao, L.; Hua, H.M.; Pei, Y.H. Sg17–1-4, a novel isocoumarin from a marine fungus Alternaria tenuis Sg17–1. J. Antibiot. 2006, 59, 355–357. [Google Scholar] [CrossRef]
- Aly, A.H.; Edrada-Ebel, R.; Indriani, I.D.; Wray, V.; Muller, W.E.; Totzke, F.; Zirrgiebel, U.; Schachtele, C.; Kubbutat, M.H.; Lin, W.H.; et al. Cytotoxic metabolites from the fungal endophyte Alternaria sp. and their subsequent detection in its host plant Polygonum senegalense. J. Nat. Prod. 2008, 71, 972–980. [Google Scholar] [CrossRef]
- Liu, Z.Z.; Zhu, J.; Sun, B.; Liu, S.; Geng, S.; Liu, X.; Li, C.L. Alternol inhibits proliferation and induces apoptosis in mouse lymphocyte leukemia (L1210) cells. Mol. Cell Biochem. 2007, 306, 115–122. [Google Scholar] [CrossRef]
- Zhao, J.; Li, C.; Wang, W.; Zhao, C.; Luo, M.; Mu, F.; Fu, Y.; Zu, Y.; Yao, M. Hypocrea lixii, novel endophytic fungi producing anticancer agent cajanol, isolated from pigeon pea (Cajanus cajan [L.] Millsp.). J Appl. Microbiol. 2013, 115, 102–113. [Google Scholar] [CrossRef]
- Du, L.; Zhu, T.J.; Li, L.Y.; Cai, S.X.; Zhao, B.Y.; Gu, Q.Q. Cytotoxic sorbicillinoids and bisorbicillinoids from a marine-derived fungus Trichoderma sp. Chem. Pharm. Bull. 2009, 57, 220–223. [Google Scholar] [CrossRef]
- Lan, W.J.; Zhao, Y.; Xie, Z.L.; Liang, L.Z.; Shao, W.Y.; Zhu, L.P.; Yang, D.P.; Zhu, X.F.; Li, H.-J. Novel sorbicillin analogues from the marine fungus Trichoderma sp. associated with the seastar Acanthaster planci. Nat. Prod. Commun. 2012, 7, 1337–1340. [Google Scholar] [CrossRef]
- Ma, L.; Liu, W.; Huang, Y.; Rong, X. Two acid sorbicillin analogues from saline lands-derived fungus Trichoderma sp. J. Antibiot. 2011, 64, 645–647. [Google Scholar] [CrossRef]
- Liu, W.; Gu, Q.; Zhu, W.; Cui, C.; Fan, G. Two new benzoquinone derivatives and two new bisorbicillinoids were isolated from a marine-derived fungus Penicillium terrestre. J. Antibiot. 2005, 58, 441–446. [Google Scholar] [CrossRef]
- Liu, W.; Gu, Q.; Zhu, W.; Cui, C.; Fan, G. Dihydrotrichodimerol and tetrahydrotrichodimerol, two new bisorbicillinoids, from a marine-derived Penicillium terrestre. J. Antibiot. 2005, 58, 621–624. [Google Scholar] [CrossRef]
- Ying, Y.M.; Zhan, Z.J.; Ding, Z.S.; Shan, W.G. Bioactive metabolites from Penicillium sp. P-1, a fungal endophyte in Huperzia serrata. Chem. Nat. Compd. 2011, 47, 541–544. [Google Scholar] [CrossRef]
- Li, D.; Cai, S.; Zhu, T.; Wang, F.; Xiao, X.; Gu, Q. New cytotoxic metabolites from a deep-sea-derived fungus, Phialocephala sp., strain FL30r. Chem. Biodivers. 2011, 8, 895–901. [Google Scholar] [CrossRef]
- Li, D.; Cai, S.; Zhu, T.; Wang, F.; Xiao, X.; Gu, Q. Three new sorbicillin trimers, trisorbicillinones B, C, and D, from a deep ocean sediment derived fungus, Phialocephala sp. FL30r. Tetrahedron 2010, 66, 5101–5106. [Google Scholar] [CrossRef]
- Li, D.; Wang, F.; Xiao, X.; Fang, Y.; Zhu, T.; Gu, Q.; Zhu, W. Trisorbicillinone A, a novel sorbicillin trimer, from a deep sea fungus, Phialocephala sp. FL30r. Tetrahedron Lett. 2007, 48, 5235–5238. [Google Scholar] [CrossRef]
- Li, D.; Wang, F.; Cai, S.; Zeng, X.; Xiao, X.; Gu, Q.; Zhu, W. Two new bisorbicillinoids isolated from a deep-sea fungus, Phialocephala sp. FL30r. J. Antibiot. 2007, 60, 317–320. [Google Scholar] [CrossRef] [PubMed]
- Yao, Y.; Li, J.; Jiang, C.S.; Zhao, X.X.; Miao, Z.H.; Liu, H.T.; Zheng, P.; Yao, W.X.; Li, W.Q. Trichodimerol and sorbicillin induced apoptosis of HL-60 cells is mediated by reactive oxygen species. Pharmazie 2015, 70, 394–398. [Google Scholar] [PubMed]
- Bringmann, G.; Lang, G.; Gulder, T.A.M.; Tsuruta, H.; Mühlbacher, J.; Maksimenka, K.; Steffens, S.; Schaumann, K.; Stohr, R.; Wiese, J.; et al. The first sorbicillinoid alkaloids, the antileukemic sorbicillactones A and B, from a sponge-derived Penicillium chrysogenum strain. Tetrahedron 2005, 61, 7252–7265. [Google Scholar] [CrossRef]
- Rehman, S.U.; Yang, L.J.; Zhang, Y.H.; Wu, J.S.; Shi, T.; Haider, W.; Shao, C.L.; Wang, C.Y. Sorbicillinoid derivatives from sponge-derived fungus Trichoderma reesei (HN-2016-018). Front. Microbiol. 2020, 11, 1334. [Google Scholar] [CrossRef] [PubMed]
- Li, X.G.; Pan, W.D.; Lou, H.Y.; Liu, R.M.; Xiao, J.H.; Zhong, J.J. New cytochalasins from medicinal macrofungus Crodyceps taii and their inhibitory against human cancer cells activities. Bioorg. Med. Chem. Lett. 2015, 25, 1823–1826. [Google Scholar] [CrossRef]
- Arora, D.; Sharma, N.; Singamaneni, V.; Sharma, V.; Kushwaha, M.; Abrol, V.; Guru, S.; Sharma, S.; Gupta, A.P.; Bhushan, S.; et al. Isolation and characterization of bioactive metabolites from Xylaria psidii, an endophytic fungus of the medicinal plant Aegle marmelos and their role in mitochondrial dependent apoptosis against pancreatic cancer cells. Phytomedicine 2016, 23, 1312–1320. [Google Scholar] [CrossRef]
- Yedukondalu, N.; Arora, P.; Wadhwa, B.; Malik, F.A.; Vishwakarma, R.A.; Gupta, V.K.; Riyaz-Ul-Hassan, S.; Ali, A. Diapolic acid A–B from an endophytic fungus, Diaporthe terebinthifolii depicting antimicrobial and cytotoxic activity. J. Antibiot. 2017, 70, 212–215. [Google Scholar] [CrossRef]
- Luo, D.Q.; Zhang, L.; Shi, B.Z.; Song, X.M. Two new oxysporone derivatives from the fermentation broth of the endophytic plant fungus Pestalotiopsis karstenii isolated from stems of Camellia sasanqua. Molecules 2012, 17, 8554–8560. [Google Scholar] [CrossRef]
- Momesso, L.S.; Kawano, C.Y.; Ribeiro, P.H.; Nomizo, A.; Goldman, G.H.; Pupo, T.M. Chaetoglobosins produced by Chaetomium globosum, endophytic fungus found in association with Viguiera robusta Gardn (Asteraceae). Quim. Nova 2008, 31, 1680–1685. [Google Scholar] [CrossRef]
- Li, H.; Xiao, J.; Gao, Y.; Tang, J.J.; Zhang, A.L.; Gao, J.M. Chaetoglobosins from Chaetomium globosum, an endophytic fungus in Ginkgo biloba, and their phytotoxic and cytotoxic activities. J. Agric. Food Chem. 2014, 62, 3734–3741. [Google Scholar] [CrossRef]
- Hawas, U.W.; Abou El-Kassem, L.; Ahmed, E.F.; Alghamdi, R.A. Bioactive sulfonyl metabolites from the Red Sea endophytic fungus Penicillium aculeatum. Nat. Prod. Res. 2021, 36, 1–9. [Google Scholar] [CrossRef]
- Cai, X.Y.; Wang, J.P.; Shu, Y.; Hu, J.T.; Sun, C.T.; Cai, L.; Ding, Z.T. A new cytotoxic indole alkaloid from the fungus Penicillium polonicum TY12. Nat. Prod. Res. 2020, 36, 2270–2276. [Google Scholar] [CrossRef]
- Gubiani, J.R.; Oliveira, M.C.S.; Neponuceno, R.A.R.; Camargo, M.J.; Garcez, W.S.; Biz, A.R.; Soares, M.A.; Araujo, A.R.; Bolzani, V.D.S.; Lisboa, H.C.F.; et al. Cytotoxic prenylated indole alkaloid produced by the endophytic fungus Aspergillus terreus P63. Phytochem. Lett. 2019, 32, 162–167. [Google Scholar] [CrossRef]
- Scopel, M.; Mothes, B.; Lerner, C.B.; Henriques, A.T.; Macedo, A.J.; Abraham, W.R. Arvoredol—An unusual chlorinated and biofilm inhibiting polyketide from a marine Penicillium sp. of the Brazilian coast. Phytochem. Lett. 2017, 20, 73–76. [Google Scholar] [CrossRef]
- Adorisio, S.; Fierabracci, A.; Muscari, I.; Liberati, A.M.; Cannarile, L.; Thuy, T.T.; Sung, T.V.; Sohrab, H.; Hasan, C.M.; Delfino, D.V.; et al. Fusarubin and anhydrofusarubin isolated from a Cladosporium Species inhibit cell growth in human cancer cell lines. Toxins 2019, 11, 503. [Google Scholar] [CrossRef]
- Gubiani, J.R.; Bernardi, D.I.; de Pala, C.C.P.; Seleghim, M.H.R.; Ferreira, A.G.; Batista, A.N.L.; Batista, J.M., Jr.; Oliveira, L.F.P.; Lira, S.P.; Burdette, J.E.; et al. Absolute configuration of cytotoxic anthraquinones from a Brazilian cave soil-derived fungus, Aspergillus sp. SDC28. Arch. Pharm. 2022, 355, e2100441. [Google Scholar] [CrossRef]
- Kumar, A.; Patil, D.; Rajamohanan, P.R.; Ahmad, A. Isolation, purification and characterization of vinblastine and vincristine from endophytic fungus Fusarium oxysporum isolated from Catharanthus roseus. PLoS ONE 2013, 8, e71805. [Google Scholar] [CrossRef]
- Yao, Q.; Wang, J.; Zhang, X.; Nong, X.; Xu, X.; Qi, S. Cytotoxic polyketides from the deep-sea-derived fungus Engyodontium album DFFSCS021. Mar. Drugs 2014, 12, 5902–5915. [Google Scholar] [CrossRef]
- Rosa, L.H.; Gonçalves, V.N.; Caligiorne, R.B.; Alves, T.A.M.; Rabello, A.; Sales, P.A.; Romanha, A.J.; Sobral, M.E.G.; Rosa, C.A.; Zani, C.L. Leishmanicidal, trypanocidal, and cytotoxic activities of endophytic fungi associated with bioactive plants in Brazil. Braz. J. Microbiol. 2010, 41, 420–430. [Google Scholar] [CrossRef]
- Alves, D.S.; Wildson, S.; Dayanne, F.; Francisco, V.; Fábio, M.S. Antioxidant, anticholinesterasic and cytotoxic activities of metabolites of endophytic fungi. Braz. J. Dev. 2020, 6, 73684–73691. [Google Scholar] [CrossRef]
- Lou, J.; Fu, L.; Peng, Y.; Zhou, L. Metabolites from Alternaria fungi and their bioactivities. Molecules 2013, 18, 5891–5935. [Google Scholar] [CrossRef] [PubMed]
- Shaaban, M.; Shaaban, K.A.; Abdel-Aziz, M.S. Seven naphtho-γ-pyrones from the marine-derived fungus Alternaria alternata: Structure elucidation and biological properties. Org. Med. Chem. Lett. 2012, 2, 6. [Google Scholar] [CrossRef] [PubMed]
- Musetti, R.; Polizzotto, R.; Vecchione, A.; Borselli, S.; Zulini, L.; D’Ambrosio, M.; Di Toppi, L.S.; Pertot, I. Antifungal activity of diketopiperazines extracted from Alternaria alternate against Plasmopara viticola: An ultrastructural study. Micron 2007, 38, 643–650. [Google Scholar] [CrossRef] [PubMed]
- Abbas, H.K.; Riley, R.T. The presence and phytotoxicity of fumonisins and AAL-toxin in Alternaria alternata. Toxicon 1996, 34, 133–136. [Google Scholar] [CrossRef]
- Ostry, V. Alternaria mycotoxins: An overview of chemical characterization, producers, toxicity, analysis and occurrence in foodstuffs. World Mycotoxin J. 2008, 1, 175–188. [Google Scholar] [CrossRef]
- Schreck, I.; Deigendesch, U.; Burkhardt, B.; Marko, D.; Weiss, C. The Alternaria mycotoxins alternariol and alternariol methyl ether induce cytochrome P450 1A1 and apoptosis in murine hepatoma cells dependent on the aryl hydrocarbon receptor. Arch. Toxicol. 2012, 86, 625–632. [Google Scholar] [CrossRef]
- Mizushina, Y.; Maeda, N.; Kuriyama, I.; Yoshida, H. Dehydroalternusin is a specific inhibitor of mammalian DNA polymerase α. Expert Opin. Inv. Drugs 2011, 20, 1523–1534. [Google Scholar] [CrossRef]
- Fernandes, M.; Dos, R.V.; Silva, T.A.C.; Pfenning, L.H.; Costa-Neto, C.M.; Heinrich, T.A.; Alencar, S.M.; Lima, M.A.; Ikegaki, M. Biological activities of the fermentation extract of the endophytic fungus Alternaria alternata isolated from Coffea arabica L. Braz. J. Pharm. Sci. 2009, 45, 677–685. [Google Scholar] [CrossRef][Green Version]
- Bhimba, B.V.; Franco, D.A.; Mathew, J.M.; Jose, G.M.; Joel, E.L.; Thangaraj, M. Anticancer and antimicrobial activity of mangrove derived fungi Hypocrea lixii VB1. Chin. J. Nat. Med. 2012, 10, 77–80. [Google Scholar] [CrossRef]
- Duker-Eshun, G.; Jaroszewski, J.W.; Asomaning, W.A.; Oppong-Boachie, F.; Christensen, S.B. Antiplasmodial constituents of Cajanus cajan. Phytother. Res. 2004, 18, 128–130. [Google Scholar] [CrossRef]
- Liu, X.L.; Zhang, X.J.; Fu, Y.J.; Zu, Y.G.; Wu, N.; Liang, L.; Efferth, T. Cajanol inhibits the growth of Escherichia coli and Staphylococcus aureus by acting on membrane and DNA damage. Planta Med. 2011, 77, 158–163. [Google Scholar] [CrossRef]
- Cram, D.J. Mold metabolites. II. The structure of sorbicillin, a pigment produced by the mold Penicillium notatum. J. Am. Chem. Soc. 1948, 70, 4240–4243. [Google Scholar] [CrossRef]
- Hou, X.; Zhang, X.; Xue, M.; Zhao, Z.; Zhang, H.; Xu, D.; Lai, D.; Zhou, L. Recent advances in sorbicillinoids from fungi and their bioactivities (covering 2016–2021). J. Fungi 2022, 8, 62. [Google Scholar] [CrossRef]
- Meng, J.; Wang, X.; Xu, D.; Fu, X.; Zhang, X.; Lai, D.; Zhou, L.; Zhang, G. Sorbicillinoids from fungi and their bioactivities. Molecules 2016, 21, 715. [Google Scholar] [CrossRef]
- Harned, A.M.; Volp, K.A. The sorbicillinoid family of natural products: Isolation, biosynthesis and synthetic studies. Nat. Prod. Rep. 2011, 28, 1790–1810. [Google Scholar] [CrossRef]
- Ei-Elimat, T.; Raja, H.A.; Figueroa, M.; Swanson, S.M.; Falkinham, J.O.; Lucas, D.M.; Grever, M.R.; Wani, M.C.; Pearce, C.J.; Oberlies, N.H. Sorbicillinoid analogs with cytotoxic and selective anti Aspergillus activities from Scytalidium album. J. Antibiot. 2015, 68, 191–196. [Google Scholar] [CrossRef]
- Lee, D.; Lee, J.H.; Cai, X.F.; Shin, J.C.; Lee, K.; Hong, Y.S.; Lee, J.J. Fungal metabolites, sorbicillinoid polyketides and their effects on the activation of peroxisome proliferator-activated receptor γ. J. Antibiot. 2005, 58, 615–620. [Google Scholar] [CrossRef]
- Santos, S.N.; Ferraris, F.K.; de Souza, A.O.; Henriques, M.G.; Melo, I.S. Endophytic fungi from Combretum leprosum with potential anticancer and antifungal activity. Symbiosis 2012, 58, 109–117. [Google Scholar] [CrossRef]
- Liu, S.; Guo, L.; Che, Y.; Liu, L. Pestaloficiols Q–S from the plant endophytic fungus Pestalotiopsis fici. Phytotherapy 2013, 85, 114–118. [Google Scholar] [CrossRef]
- Mady, M.S.; Mohyeldin, M.M.; Ebrahim, H.Y.; Elsayed, H.E.; Houssen, W.E.; Haggag, E.G.; Soliman, R.F.; El Sayed, K.F. The indole alkaloid meleagrin, from the olive tree endophytic fungus Penicillium chrysogenum, as a novel lead for the control of c-Met-dependent breast cancer proliferation, migration and invasion. Bioorg. Med. Chem. 2016, 24, 113–122. [Google Scholar] [CrossRef]
- Miethke, M.; Pieroni, M.; Weber, T.; Brönstrup, M.; Hammann, P.; Halby, L.; Arimondo, P.B.; Glaser, P.; Aigle, B.; Mülleet, R.; et al. Towards the sustainable discovery and development of new antibiotics. Nat. Rev. Chem. 2021, 5, 726–749. [Google Scholar] [CrossRef] [PubMed]
- Yu, G.; Sun, Z.; Peng, J.; Zhu, M.; Che, Q.; Zhang, G.; Li, D. Secondary metabolites produced by combined culture of Penicillium crustosum and a Xylaria sp. J. Nat. Prod. 2019, 82, 2013–2017. [Google Scholar] [CrossRef] [PubMed]
- Qin, Y.Y.; Huang, X.S.; Liu, X.B.; Mo, T.X.; Xu, Z.L.; Li, B.C.; Qin, X.Y.; Li, J.; Schaberle, T.F.; Yang, R.Y. Three new andrastin derivatives from the endophytic fungus Penicillium vulpinum. Nat. Prod. Res. 2020, 36, 3262–3270. [Google Scholar] [CrossRef] [PubMed]
- Pinheiro, E.A.; Borges, F.C.; Pina, J.R.; Ferreira, L.R.; Cordeiro, J.S.; Carvalho, J.M.; Feitosa, A.O.; Campos, F.R.; Barison, A.; Souza, A.D.L.; et al. Annularins I and J: New metabolites isolated from endophytic fungus Exserohilum rostratum. J. Braz. Chem. Soc. 2016, 27, 1432–1436. [Google Scholar] [CrossRef]
- Pina, J.R.S.; Silva-Silva, J.V.; Carvalho, J.M.; Bitencourt, H.R.; Watanabe, L.A.; Fernandes, J.M.P.; Souza, G.E.d.; Aguiar, A.C.C.; Guido, R.V.C.; Almeida-Souza, F.; et al. Antiprotozoal and antibacterial activity of ravenelin, a xanthone isolated from the endophytic fungus Exserohilum rostratum. Molecules 2021, 26, 3339. [Google Scholar] [CrossRef] [PubMed]
- Pang, X.J.; Zhang, S.B.; Chen, H.L.; Zhao, W.T.; Yang, D.F.; Xian, P.J.; Xu, L.L.; Tao, Y.D.; Fu, H.Y.; Yang, X.L. Emericelactones A-D: Four novel polyketides produced by Emericella sp. XL 029, a fungus associated the leaves of Panax notoginseng. Tetrahedron Lett. 2018, 59, 4566–4570. [Google Scholar] [CrossRef]
- Pang, X.J.; Zhang, S.B.; Xian, P.J.; Wu, X.; Yang, D.F.; Fu, H.Y.; Yang, X.L. Emericellins A and B: Two sesquiterpenoids with an unprecedented tricyclo[4,4,2,1]hendecane scaffold from the liquid cultures of endophytic fungus Emericella sp. XL 029. Fitoterapia 2018, 131, 55–58. [Google Scholar] [CrossRef]
- Duan, X.X.; Qin, D.; Song, H.C.; Gao, T.C.; Zuo, S.H.; Yan, X.; Wang, J.Q.; Ding, X.; Di, Y.T.; Dong, J.Y. Irpexlacte AD, four new bioactive metabolites of endophytic fungus Irpex lacteus DR10-1 from the waterlogging tolerant plant Distylium chinense. Phytochem. Lett. 2019, 32, 151–156. [Google Scholar] [CrossRef]
- Chen, J.; Bai, X.; Hua, Y.; Zhang, H.; Wang, H. Fusariumins C and D, two novel antimicrobial agents from Fusarium oxysporum ZZP-R1 symbiotic on Rumex madaio Makino. Phytotherapy 2019, 134, 1–4. [Google Scholar] [CrossRef]
- Ibrahim, S.R.; Mohamed, G.A.; Al Haidari, R.A.; Zayed, M.F.; El-Kholy, A.A.; Elkhayat, E.S.; Ross, S.A. Fusarithioamide B, a new benzamide derivative from the endophytic fungus Fusarium chlamydosporium with potent cytotoxic and antimicrobial activities. Bioorg. Med. Chem. 2018, 26, 786–790. [Google Scholar] [CrossRef]
- Khan, N.; Afroz, F.; Begum, M.N.; Rony, S.R.; Sharmin, S.; Moni, F.; Sohrab, M.H. Endophytic Fusarium solani: A rich source of cytotoxic and antimicrobial napthaquinone and aza-anthraquinone derivatives. Toxicol. Rep. 2018, 5, 970–976. [Google Scholar] [CrossRef]
- Zhang, H.; Ruan, C.; Bai, X.; Zhang, M.; Zhu, S.; Jiang, Y. Isolation and identification of the antimicrobial agent beauvericin from the endophytic F5-19 with NMR and ESI-MS/MS. BioMed. Res. Int. 2016, 2016, 1084670. [Google Scholar] [CrossRef]
- Deng, Z.; Li, C.; Luo, D.; Teng, P.; Guo, Z.; Tu, X.; Zou, K.; Gong, D. A new cinnamic acid derivative from plant-derived endophytic fungus Pyronema sp. Nat. Prod. Res. 2017, 31, 2413–2419. [Google Scholar] [CrossRef]
- Shin, T.Y.; Bae, S.M.; Woo, S.D. Screening and characterization of antimicrobial substances originated from entomopathogenic fungi. J. Asia-Pac. Entomol. 2016, 19, 1053–1059. [Google Scholar] [CrossRef]
- Mohamed, G.A.; Ibrahim, S.R.M.; Alhakamy, N.A.; Aljohani, O.S. Fusaroxazin, a novel cytotoxic and antimicrobial xanthone derivative from Fusarium oxysporum. Nat. Prod. Res. 2020, 36, 952–960. [Google Scholar] [CrossRef]
- Jayasinghe, L.; Abbas, H.K.; Jacob, M.R.; Herath, W.H.; Nanayakkara, N.P. N-Methyl-4-hydroxy-2-pyridinone analogues from Fusarium oxysporum. J. Nat. Prod. 2006, 69, 439–442. [Google Scholar] [CrossRef]
- Sudharshana, T.N.; Venkatesh, H.N.; Nayana, B.; Manjunath, K.; Mohana, D.C. Anti-microbial and anti-mycotoxigenic activities of endophytic Alternaria alternata isolated from Catharanthus roseus (L.) G. Don.: Molecular characterisation and bioactive compound isolation. Mycology 2018, 10, 40–48. [Google Scholar] [CrossRef]
- Macelroy, R.D. Some comments on the evolution of extremophiles. Biosystems 1974, 6, 74–75. [Google Scholar] [CrossRef]
- Dhakar, K.; Pandey, A. Wide pH range tolerance in extremophiles: Towards understanding an important phenomenon for future biotechnology. Appl. Microbiol. Biotechnol. 2016, 100, 2499–2510. [Google Scholar] [CrossRef]
- Zhang, X.; Li, S.J.; Li, J.J.; Liang, Z.Z.; Zhao, C.Q. Novel natural products from extremophilic fungi. Mar. Drugs 2018, 16, 194. [Google Scholar] [CrossRef]
- Coker, J.A. Extremophiles and biotechnology: Current uses and prospects. F1000Research 2016, 5, 396. [Google Scholar] [CrossRef] [PubMed]
- Anwar, U.B.; Zwar, I.P.; de Souza, A.O. Biomolecules produced by extremophiles microorganisms and recent discoveries. In New and Future Developments in Microbial Biotechnology and Bioengineering: Microbial Biomolecules: Properties, Relevance, and Their Translational Applications; Rodrigues, A.G., Ed.; Elsevier: Amsterdam, The Netherlands, 2018; pp. 247–269. [Google Scholar] [CrossRef]
- Baranova, A.A.; Alferova, V.A.; Korshuna, V.A.; Tyurina, A.P. Antibiotics from extremophilic micromycetes. Russ. J. Bioorg. Chem. 2020, 46, 903–971. [Google Scholar] [CrossRef] [PubMed]
- Rogozhin, E.A.; Sadykova, V.S.; Baranova, A.A.; Vasilchenko, A.S.; Lushpa, V.A.; Mineev, K.S.; Georgieva, M.L.; Kul’ko, A.B.; Krasheninnikov, M.E.; Andreev, Y.A. A novel lipopeptaibol emericellipsin A with antimicrobial and antitumor activity produced by the extremophilic fungus Emericellopsis alkalina. Molecules 2018, 23, 2785. [Google Scholar] [CrossRef] [PubMed]
- Selbmann, L.; Benkő, Z.; Coleine, C.; de Hoog, S.; Donati, C.; Druzhinina, I.; Emri, T.; Ettinger, C.L.; Gladfelter, A.S.; Gorbushina, A.A.; et al. Shed light in the DaRk LineagES of the fungal tree of life—Stres. Life 2020, 10, 362. [Google Scholar] [CrossRef]
- Orwa, P.; Mugambi, G.; Wekesa, V.; Mwirichia, R. Isolation of haloalkaliphilic fungi from Lake Magadi in Kenya. Heliyon 2020, 6, e02823. [Google Scholar] [CrossRef]
- Menezes, G.C.A.; Porto, B.A.; Amorim, S.S.; Zani, C.L.; Alves, T.M.A.; Sales, P.A., Jr.; Murta, S.M.F.; Simôes, J.C.; Cota, B.B.; Rosa, C.A.; et al. Fungi in glacial ice of Antarctica: Diversity, distribution and bioprospecting of bioactive compounds. Extremophiles 2020, 24, 367–376. [Google Scholar] [CrossRef]
- Khan, I.; Zhang, H.; Liu, W.; Zhang, L.; Peng, F.; Zhang, Q.; Zhang, G.; Zhang, W.; Zhang, C. Identification and bioactivity evaluation of secondary metabolites from Antarctic-derived Penicillium chrysogenum CCTCC M 2020019. RSC Adv. 2020, 10, 20738–20744. [Google Scholar] [CrossRef]
- Wang, C.; Tang, S.; Cao, S. Antimicrobial compounds from marine fungi. Phytochem. Rev. 2021, 20, 85–117. [Google Scholar] [CrossRef]
- Van Boeckel, T.P.; Brower, C.; Gilbert, M.; Grenfell, B.T.; Levin, S.A.; Robinson, T.P.; Teillant, A.; Laxminarayan, R. Global trends in antimicrobial use in food animals. Proc. Natl. Acad. Sci. USA 2015, 112, 5649–5654. [Google Scholar] [CrossRef]

| Metabolites | Fungi Species | References |
|---|---|---|
| Oxalicine C, penicierythritol A | P. chrysogenum XNM-12 | [7] |
| Stemphyperylenol | B. dothidea | [135] |
| Alterperylenol, stemphyperylenol, 7-acetyl-1,3,6-trihydroxyanthracene-9,10-dione, (11S)-1,3,6-trihydroxy-7-(1-hydroxyethyl)anthracene-9,10-dione, and 7-acetyl-1,3,6-trihydroxyanthracene-9,10-dione | Alternaria sp. | [136] |
| Pensulfonoxy, pensulfonamide | P. aculeatum | [176] |
| Cyclopenol, verrucosidin and fructigenine A, polonide A | P. polonicum TY12 | [177] |
| Arvoredol | Penicillium sp. F37 | [179] |
| Fusarubin | Cladosporium sp. | [180] |
| Engyodontiumones H, aspergillusone B, AGI-B4 | E. album DFFSCS021 | [183] |
| 1,3-dihydroxy-5-(12-hydroxyheptadecyl)benzene, 1,3-dihydroxy-5-(12 sulfoxyheptadecyl)benzene, and penixillarins B and C | Coculture of P. crustosum PRB-2 and Xylaria sp. HDN13-249A | [207] |
| 10-formyl andrastone A, 10-dymethylated andrastone A, 15-deacetylated citreohybridone E, citreohybridonol, andrastins A and B | P. vulpinum | [208] |
| Ergosterol peroxide, monocerin, annularin I and J, ravenelin | E. rostratum | [209,210] |
| Emericelactone A-D, emericellins A and B | Emericella sp. XL 029 | [211,212] |
| Irpexlacte A, furan derivatives irpexlacte B (5-(2α-hydroxypentyl) furan-2-carbaldehyde), irpexlacte C (5-(1α-hydroxypentyl) furan-2-carbaldehyde), irpexlacte D (5-(5-(2-hydroxypropanoyl) furan-2-yl) pentan-2-one) | I. lacteus DR10-1 | [213] |
| Fusariumins C and D | F. oxysporum ZZP-R1 | [214] |
| Fusarithioamide B | F. chlamydosporium | [215] |
| Anhydrofusarubin, fusarubin, 3-deoxyfusarubin, bostrycoidin, ergosterol, 3,5,9-trihydroxyergosta-7,22-diene-6-one, 4-hydroxybenzaldehyde | F. solani | [216] |
| Beauvericin | F. oxysporum EPH2RAA and CEC1S F. oxysporum 5-19 | [148,217] |
| 4-hydroxycinnamic acid derivative, methyl 2-{(E)-2-[4-(formyloxy)phenyl]ethenyl}-4-methyl-3-oxopentanoate | Pyronema sp. A2-1 Pyronema sp. D1-2 | [218] |
| p-Coumaric acid | A. alternata | [219] |
Publisher’s Note: MDPI stays neutral with regard to jurisdictional claims in published maps and institutional affiliations. |
© 2022 by the authors. Licensee MDPI, Basel, Switzerland. This article is an open access article distributed under the terms and conditions of the Creative Commons Attribution (CC BY) license (https://creativecommons.org/licenses/by/4.0/).
Share and Cite
Conrado, R.; Gomes, T.C.; Roque, G.S.C.; De Souza, A.O. Overview of Bioactive Fungal Secondary Metabolites: Cytotoxic and Antimicrobial Compounds. Antibiotics 2022, 11, 1604. https://doi.org/10.3390/antibiotics11111604
Conrado R, Gomes TC, Roque GSC, De Souza AO. Overview of Bioactive Fungal Secondary Metabolites: Cytotoxic and Antimicrobial Compounds. Antibiotics. 2022; 11(11):1604. https://doi.org/10.3390/antibiotics11111604
Chicago/Turabian StyleConrado, Rafael, Tainah Colombo Gomes, Gabriella Sales Calaço Roque, and Ana Olívia De Souza. 2022. "Overview of Bioactive Fungal Secondary Metabolites: Cytotoxic and Antimicrobial Compounds" Antibiotics 11, no. 11: 1604. https://doi.org/10.3390/antibiotics11111604
APA StyleConrado, R., Gomes, T. C., Roque, G. S. C., & De Souza, A. O. (2022). Overview of Bioactive Fungal Secondary Metabolites: Cytotoxic and Antimicrobial Compounds. Antibiotics, 11(11), 1604. https://doi.org/10.3390/antibiotics11111604

